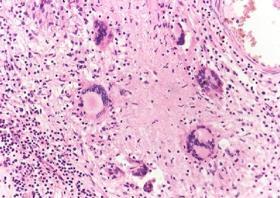
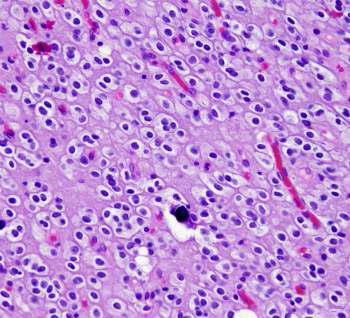
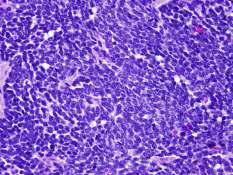
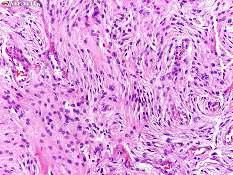
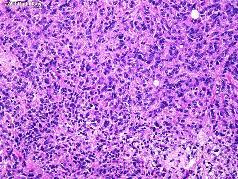

CNS















❖ Produced by choroid plexus in the lateral ventricles.
❖ Pass from the lateral to the third ventricle through foramina of Monro (interventricular foramen).
❖ Pass from the third to the fourth ventricle through aqueduct of Sylvius.

❖ Passes from the fourth ventricle to the sub- arachnoids space through foramina of Magendie and Luschka.



❖ CSF then drains to the superior sagittal sinus through the arachnoid villi or granulations.
❖ Abnormal dilatation of the ventricular system by excess CSF with atrophy of the brain tissue. I. Increased CSF production: Coroid plexuses tumor as papilloma.
Obstrution of CSF flow: Congenital causes: 1. Stenosis of the aqueduct cerebri; foramina of Monro and Sylvius.
2. Stenosis of the foramina of fourth ventricle;foramina of Magendie and Luschka.
3. Arnold-Chiari malformation (A Chiari malformation, previously called an Arnold-Chiari malformation, is where the lower part of the brain pushes down into the spinal canal). III. Decreased CSF drainage or absorption:
A. Congenital causes: Aplasia of arachinoid villi. B. Aquired causes: 1. Damage of arachnoid villi by inflammatory exudate or fibrosis. 2. Obliteration of the subarachnoid space by subtentorial space occupying lesion→ pushes the brain up against the skull bones. 3. Thrombosis of the superior sagittal sinus.
1. Communicating hydrocephalus:
❖ The obstruction is in the subarachnoid space around the mid-brain. ❖ CSF can pass from the ventricular system to the subarachenoid space. 2. Non-communicating hydrocephalus:
Types Clinical feature


❖ The obstruction is within the ventricular system or in the roof of the fourth ventricle.

1. Dysphagia, laryngeal dysfunction
2. Visual disturbances
3. Hearing impairments
4. Weakness or numbness of the face.
5. Difficulties with balance and walking.


❖ It is an excess accumulation of fluid in the intracellular or extracellular spaces of the brain.
❖ It is an accumulation of excess fluid within the brain parenchyma.

❖ Cerebral edema can result from trauma to the brain or from nontraumatic causes such as ischemic stroke, tumors, or Inflammation due to meningitis or encephalitis.
❖ Vasogenic edema.
❖ The blood-brain barrier (BBB) or the blood-cerebrospinal fluid (CSF) barrier may break down, allowing fluid to accumulate in the brain's extracellular space.


❖ Altered metabolism may cause brain cells to retain water, and dilution of the plasma may cause excess water to move into the brain cells.
❖ Fast travel to high altitude without proper acclimatization can cause highaltitude cerebral edema.
❖ The brain becomes soft and smooth and overfills the cranial vault, gyri (ridges) become flattened, sulci (grooves) become narrowed, and ventricular cavities become compressed.
❖ Symptoms include nausea, vomiting, blurred vision, faintness, and in severe cases, seizures and coma.


❖ If brain herniation occurs, respiratory symptoms or respiratory arrest can also occur due to compression of the respiratory centers in the pons and medulla oblongata.
➢ Types of vasogenic edema:
❖ Edema occurs when the integrity of the normal blood-brain barrier BBB is disturbed due to breakdown of the tight endothelial junctions that make up the barrier.
❖ This allows subsequent increase in the vascular permeability with escape of intravascular proteins and fluid into the parenchymal extracellular space.
❖ Once plasma constituents and water cross the BBB → enter the white matter → move extracellularly → edema spreads and can affect the gray matter.
❖ This may be quite rapid and extensive.
❖ Mechanisms contributing to BBB dysfunction include physical disruption by hypertension, cerebral ischemia, trauma, and tumorfacilitated release of vasoactive and endothelial destructive compounds (e.g. arachidonic acid, excitatory neurotransmitters, eicosanoids, bradykinin, histamine, and free radicals), and focal inflammation.
❖ Edema can be either localized adjacent to inflammation or tumors or generalized.
➢ Subtypes of vasogenic edema:
❖ This form of cerebral edema is seen in cases of malignant hypertension.
❖ It results from direct transmission of pressure to the cerebral capillaries with transudation of fluid from the capillaries into the extravascular compartment.
2. Cerebral edema from brain tumors:
❖ Glioma can increase secretion of VEGF, which weakens the junctions of the BBB.
❖ Dexamethasone can be of benefit in reducing VEGF secretion.
❖ It is severe and sometimes fatal form of altitude sickness that results from capillary fluid leakage due to the effects of hypoxia on the mitochondria rich endothelial cells of the BBB.
❖ Symptoms include headache, loss of coordination (ataxia), weakness, disorientation, memory loss, psychotic symptoms (hallucinations and delusions), coma and death.
❖ It is an ↑ in the intra-cellular fluid secondary to neural, glial, or endothelial cell membrane injury e.g., generalized, hypoxic/ischemic insult, or exposure to some toxins.
❖ Cytotoxic edema is seen with various toxins, Reye's syndrome, severe hypothermia, early ischemia, encephalopathy, early stroke or hypoxia, cardiac arrest, and pseudotumor cerebri.
❖ Cytotoxic edema is dominant immediately following an injury or infarct, but gives way to vasogenic edema that can persist for several days or longer.
❖ (Reye's syndrome is a very rare disorder mainly affects children and young adults under 20 years of age, that can cause serious liver and brain damage. It may lead to permanent brain injury or death).

❖ Normally, the osmolality of CSF and extracellular fluid in the brain is slightly lower than that of plasma.
❖ Plasma can be diluted by several mechanisms, including excessive water intake, syndrome of inappropriate ADH secretion, hemodialysis, or rapid reduction of blood glucose in hyperosmolar hyperglycemia, (hyperosmolar non-ketotic acidosis).
❖ Plasma dilution decreases serum osmolality, resulting in a higher osmolality in the brain compared to the serum.
❖ This creates an abnormal pressure gradient and movement of water into the brain, which can cause progressive cerebral edema, resulting in headache, ataxia, seizures and coma.




❖ Persistent headache


❖ Vomiting

❖ Blurred vision
1. Flattened brain convolution on the same side of lesion.
2. Shift of midline structures to the opposite side.
3. Papilledema: due to compression of retinal veins in the subarachnoid space.
4. Thinning of skull bone over the lesion in chronic cases.
5. Intracranial herniation:
❖ Tentorial herniation.
❖ Tonsillar herniation.
❖ Herniation of the cerebrum through tentorium cerebelli.
❖ Occurs when the space occupying lesion is located above tentorium cerebelli.
➢ Effects:
❖ Compression of midbrain and aqueduct of Sylvius → hydrocephalus.
❖ Compression of forth and sixth cranial nerves → distorted eye movement.
❖ Compression of posterior cerebral artery → posterior cerebral infarction.
❖ Herniation of the brain stem through foramen magnum.
➢ Effects:
❖ Compression of medulla oblongata → sudden death.


✓ Identify definition and etiology of cerebral ischemia.
✓ Enumerate types and effects of cerebral ischemia
✓ Describe gross and microscopic features of cerebral infarction.
✓ Classify intracranial hemorrhage
✓ Mention causes of intracranial hemorrhage
✓ Compare between epidural and subdural Hemorrhage.
✓ Enumerate types of cerebral aneurysms
✓ Identify complications of cerebral aneurysms.
Cerebrovascular diseases constitute a broad category of brain disorders; caused by pathologic processes that involve blood vessels. They constitute a major cause of neurological mortality and morbidity.
Three main categories are: 1. Cerebral ischemia and infarction 2. Intracranial hemorrhage 3. Cerebral aneurysm
The brain is a highly oxygen-dependent tissue. Cerebral blood flow normally remains stable over a wide range of blood pressure and intracranial pressure because of vascular autoregulation.

⚫ Brain ischemia has two main patterns: 1. Global cerebral ischemia

Means: widespread ischemic / hypoxic injury of brain.



Etiology: Occurs due to severe systemic hypotension (systolic pressures < 50 mmHg) as in cases of cardiac arrest and different types of shock.
Fate: depends on severity and duration of the insult.
-Mild ischemia induces only a transient post-ischemic confusion state, with eventual complete recovery.
-Severe ischemia induces wide neuronal death. Patients who survive usually have severe neurological impairment. Other patients meet the clinical criteria for brain death
Means : focal ischemia of a zone of brain tissue due to occlusion of feeding artery.
Vascular collaterals of the brain are minimal or deficient; so branches of cerebral arteries are termed end arteries.
Arterial occlusion leads first to focal ischemia and then to infarction
Etiology : focal cerebral ischemia occurs due to either:
➢ Cerebral embolism : Sources of emboli are:
- Emboli from the heart : cardiac mural thrombi, myocardial dysfunction, valvular disease, and atrial fibrillation.
- Emboli from big arteries : atheromatous plaques of carotid arteries or aortic arch.
➢ Cerebral thrombosis : occurs on top atherosclerotic plaques of cerebral arteries commonly carotid bifurcation.
- Grossly: The macroscopic appearance changes over time:
⚫
In early hours; brain tissue looks normal

⚫ After 48 hours, the tissue becomes pale, soft and swollen.

⚫ From 1-3 weeks, the tissue liquefies, eventually leaving a fluid-filled cavity.
-Microscopically;
⚫
After 12 hours, nuclear pyknosis and ischemic neuronal change with disintegration of myelin sheath.
⚫ After 48 hours, infiltration by neutrophils followed by macrophages.















✓ Meningitis
✓ Brain Abscess.
✓ Encephalitis.



Meningitis means inflammation of the meningeal coverings of the brain and spinal cord.

Inflammation of the dura is rare and called pachymeningitis.

Inflammation of the pia, arachnoid is much more common, and is called leptomeningitis.
Meningococci:

The commonest causative organisms of meningococcal meningitis. Affects specially infants, children and young adults and takes sporadic or epidemic forms.
Droplet infection takes place from patient or carrier and causes nasopharyngitis.
The organisms in the nasopharynx invade the blood stream and are carried to the meninges and choroid plexus.



Streptococci, staphylococci, pneumococci and influenza bacilli: Rare causes for septic meningitis. They reach the meninges by the following routes:

The brain is swollen and edematous.
The meningeal and cortical vessels are dilated and congested.
The exudate is most abundant at the base of the brain and on the posterior surface of the cord due to gravity.
The ventricles are dilated and the CSF is turbid as it is mixed with pus.
The subarachnoid space is filled with a yellowish purulent exudate.
The ependymal lining is necrotic, rough and the choroid plexus is congested.
➢
The subarachnoid space shows dilated congested vessels.
➢ Heavy infiltration by PML with some macrophages, lymphocytes and plasma cells among scanty fibrin threads.



Increased intracranial tension.



Presence of many P.N.Ls, pus cells and bacteria.
Elevated protein content.
Decreased sugar content.
➢ Thrombosis of the pial arteries causes infarctions in the brain and spinal cord.



➢ Healing by fibrosis results in adhesions and obstruction of the foramina of Luschka and Magendie which cause:

Compression of the cranial nerves; III, IV, VI and spinal nerve roots leading to diplopia, squint, ptosis.

Obstruction of the flow of C.S.F. leading to hydrocephalus.
Septic thrombophlebitis: Causes septicemia and systemic pyemia.
Blood spread of bacteria: Causes acute bacterial endocarditis, pericarditis, empyema and arthritis.
Adrenal cortical hemorrhage: In severe cases causing acute adrenal cortical insufficiency (Waterhouse-Friderichsen syndrome).
Less fulminate clinical course than septic meningitis.
Self-limited and often treated symptomatically.

There are no distinctive macroscopic findings except for brain swelling, which may be seen in only some instances.
On microscopic examination, there is either no recognizable abnormality or a mild to moderate leptomeningeal lymphocytic infiltrate.



An increased number of lymphocytes.


The protein elevation is only moderate. Glucose content is nearly always normal.
Commonly due to entero-virus infection.
More common in children and affects the pia-arachnoid, its blood vessels and the superficial layer of the brain.
It is due to blood spread of a tuberculous focus in the body. It is one of the causes of arachnoid fibrosis which may produce hydrocephalus.
Yellowish exudate covers the surface of the brain and is marked over the base.
Exudate is composed of fibrin, epithelioid cells, lymphocytes, scanty giant cells and shows areas of caseation.
Healing by fibrosis may obstruct the roof of the fourth ventricle causing hydrocephalus.
The meninges covering the spinal cord particularly in the cervical region show similar changes. Tubercles on the small blood vessels of the brain, choroid plexus and lining of the ventricular cavities.
Areas of softening in the cerebral cortex and basal ganglia, this result from tuberculous end arteritis followed by thrombosis.





The fluid is clear and a fine web of fibrin forms on the surface on standing.
Moderate increase in mononuclear cells, mainly lymphocytes. Protein level is elevated.
Glucose content is moderately reduced or normal.
Small number of bacilli could be detected in smears.
Increased intracranial tension. Compression of the cranial nerves leading to their paralysis. Hydrocephalus. May result in well circumscribed mass in the brain substance itself called tuberculoma. Miliary tuberculosis.
From otitis media, sinusitis and mastoiditis.




From acute bacterial endocarditis, bronchiectasis, lung abscess or empyema through vertebral system of veins.
Through compound fractures of the skull.

Otitis media causes temporal or parietal lobe abscess.
Mastoiditis causes cerebellar abscess.
Sinusitis, lung infection and fracture causes frontal lobe abscess.
The site of abscess depends upon the primary site from which infection comes
Hematogenous abscesses from systemic pyemia are multiple and found at the junction of the grey and white matter.
Early brain tissue shows edema, softening and heavy neutrophilic infiltration.
Active liquefactive necrosis is surrounded by zone of congestion. An abscess cavity filled with pus and lined by necrotic tissue develops.
Affected part appears swollen, convolutions flattened and meninges become thick and adherent.
The abscess tends to spread inwards and rupture into the ventricles.
If the pus is absorbed or evacuated, spontaneous healing occurs by gliosis, but more commonly the abscess changes to chronic one.
Chronic abscess is surrounded by a thick wall of reactive gliosis and its inner lining is smooth.
✓ Progressive focal deficits.
✓ Increases ICT and progressive herniation which may be fatal.


The CSF shows: ✓ White cell count is raised ✓ Protein level is raised ✓ Glucose content is normal ✓ Sinus thrombosis Rupture of an abscess lead to ventriculitis, meningitis, and venous

Increased intracranial tension and brain herniation.

Septic meningitis, subdural abscess, extradural abscess and sinus thrombophlebitis.

Encephalitis means inflammation of the brain.

It is caused by:
➢ Pyogenic infections as brain abscess.
➢ Bacterial toxins as botulism.
➢ Fungus infections as cryptococcosis.

➢ Parasitic infections as malaria and toxoplasmosis.
➢ Viral infections as rabies, poliomyelitis, herpes zoster and herpes simplex.


That is infection of the brain which is invariably associated with inflammation of the meninges (meningo-encephalitis).

The most characteristic features are perivascular and parenchymal mononuclear cell infiltrate.
Certain viruses may form inclusion bodies.




Definition of Neurodegeneration. Etiology & pathogenesis of neurodegenerative diseases Alzheimer’s disease, its definition, eitiology and pathological features. Parkinson’s disease. Demyelinating diseases and their classifications.

Neurodegeneration is a progressive loss of structure or function of neurons, including their deaths.
Neurodegenerative diseases: diseases that cause cellular degeneration of neurons in the brain, it causes symptoms depend on the pattern of envolvement of the brain including Parkinson's, Alzheimer's, and Huntington's. Such diseases are incurable → progressive degeneration and/or death of neuron cells.
Etiology & pathogenesis/ mechanisms:
1) Genetics:
Many neurodegenerative diseases are caused by genetic mutations, most of which are located in completely unrelated genes.
2) Protein misfolding:
Many of these diseases are associated with abnormal aggregation of mis folded proteins which may led to loss of function or trigger apoptosis .Several neurodegenerative diseases are classified as proteopathies.
Alzheimer's disease (AD), also referred to simply as Alzheimer's, is a chronic neurodegenerative disease that usually starts slowly and worsens over time
It is the cause of 60% to 70% of cases of dementia
The most common early symptom is difficulty in remembering recent events (short-term memory loss).
Etiology:
The cause of AD is poorly understood.
About 70% of the risks is believed to be genetic with many genes usually involved.
Around 0.1% of cases are familial forms of autosomal dominant inheritance, which have an onset before the age 65 years.

This form of disease is known as early onset familial Alzheimer's disease.
The oldest and most currently available drug therapies are based on Cholinergic hypothesis
It proposes that AD is caused by reduced synthesis of the neurotransmitter acetylcholine.
The cholinergic hypothesis has not maintained widespread support, largely because medications intended to treat acetylcholine deficiency is not very effective.
Amyloid hypothesis postulated that extracellular amyloid beta (Aβ) deposits are the fundamental cause of the disease.
A specific isoform of apolipoprotein, APOE4, is a major genetic risk factor for AD.
While apolipoproteins enhance the breakdown of beta amyloid, some isoforms are not very effective at this task (such as APOE4), leading to excess amyloid buildup in the brain


Exactly how disturbances of production and aggregation of the betaamyloid peptide give rise to the pathology of AD is not known
Accumulation of aggregated amyloid fibrils, which are the toxic form of the protein responsible for disrupting the cell's calcium ion homeostasis, induces apoptosis


Gyri are narrowed and sulci widened specially in frontal, temporal and parietal lobes.
The disease process is associated with Amyloid plaques and neurofibrillary tangles in the brain.
Neurofibrillary tangles; bundles of paired helical filaments in neuronal cytoplasm.
Amyloid plaque.

Brain atrophy in severe Alzheimer’s

Parkinsonism
Parkinsonism is a clinical syndrome characterized by tremors, diminished fascial expression (masked facies), slowing of voluntary movement, festinating gait (progressively shortened accelerated steps), rigidity, and postural instability.
Parkinsonism is found in Parkinson's disease (after which it is named).
The most common neurodegenerative disease associated with parkinsonism, the diagnosis is made:
In patients with progressive parkinsonism.
In the absence of a toxic or other known underlying etiology.
If they show clinical response to L-dihydroxyphenylalanine (L-DOPA) treatment.
Clinical features:
Commonly manifests as movement disorder.


Progresses producing severe motor slowing over 10-15 years.
Death usually is the result of inter current infection or trauma from frequent falls caused by postural instability.
Dementia (Lewy body dementia) arises within one year of the onset of motor symptoms.
Gross Microscopic
Pallor of the substantia nigra and locus ceruleus.


Depigmented substantia nigra.
Lewy bodies appear as single or multiple intracytoplasmic, eosinophilic, round to elongated lesions with dense core surrounded by a pale halo.
Symptoms & signs of parkinsons disease.



Demyelinating disease is any disease of the nervous system in which the myelin sheath of neurons is damaged
It is characterized by damage to the myelin with relative preservation of the axons.

This damage impairs the conduction of signals in the affected nerves.

Classification of Demyelinating diseases:
Demyelinating diseases are traditionally classified depending on the underlying reason for demyelination into two kinds: 1) Demyelinating myelinoclastic diseases. 2) Demyelinating leukodystrophic diseases.
myelinoclastic leukodystrophic


a normal and healthy myelin is attacked by an external substance, toxic, chemical or autoimmune substance.
myelin is abnormal and degenerates without attacks.
It was denominated dysmyelinating diseases.
Demyelinating disorders of the CNS
30

Multiple sclerosis is a demyelinating disease in which the myelin sheets of the nerve cells in the brain and spinal cord are damaged.
It is the most common autoimmune disorder affecting the CNS.
Etiology of MS: Autoimmune disease
A transmissible agent (virus) has been proposed but not yet identified.

Genetic factors.
Pathogenesis of MS:
The cause is not clear.
Proposed causes for this include genetics and environmental factors such as being triggered by a viral infection.
Damage of myelin sheets disrupts the ability of parts of the nervous system to communicate.

This results in a range of signs and symptoms, including physical, mental, and sometimes sychiatric problems.

The name multiple sclerosis refers to the scars known as plaques of demyelination in the nervous system.
Any area of the brain can be affected.
The lesions most commonly affect the white matter in the optic nerve, brain stem, basal ganglia, and spinal cord, or white matter tracts close to the lateral ventricles.
These plaques are perivenular and appear as irregular well demarcated grey or translucent lesions.



• Examination shows multiple areas (plaques) of demyelination in white matter of the brain and spinal cord (not the peripheral nervous system).
• The plaques are frequently located adjacent to lateral ventricles (periventricular) in the cerebral hemispheres.
• The gross coronal below has three plaques (discolored areas in white matter) indicated by arrows.

• Plaques show demyelination and tangled masses of preserved axons.
• Lymphocytic infiltration is present in areas of recent demyelination.

The disease is characterized by episodic relapses and remissions over many years.


The clinical manifestations depend on the area of the brain affected and include abnormalities of vision, cerebellar dysfunction, parasthesia, weakness and spinal cord dysfunctions
Specific symptoms include double vision, blindness in one eye, muscle weakness, trouble with sensation, or trouble with coordination.

Know the pathology of the gliomas and medulloblastoma. Identify origin, sites, gross and microscopic features of meningioma. Differentiate between different types of gliomas.

1. Astrocytes: Star-shaped, responsible for nutritional supply and insulation of neurons.
2. Oligodendrocytes: Form the myelin sheath. 3. Ependymal cells: Lining of the ventricular chambers, aqueduct, central canal of the spinal cord. 4. Microglia: Native macrophages of the CNS.


B. Neuronal cells. C. Meningeal cells. D. Endothelial cells.


Gliomas are the most common form of brain tumors, contributing to more than half of the incidence of brain tumors.
They comprise a heterogeneous group of neuroectodermal tumors that arise from the glia cells, the supporting cells of the CNS.
Astrocytes, oligodendrocytes, and ependymal cells are types of glial cells that may give rise to astrocytomas, oligodendrogliomas, and ependymomas, respectively.
It is an astrocytoma classically characterized by a biphasic pattern. Pilocytic astrocytoma accounts for 5.4% of all gliomas.
Definition
A diffusely infiltrating bbbastrocytoma typically features moderately pleomorphic cells and is characterized by a high degree of cellular differentiation and slow growth.
Most common CNS neoplasm of childhood.
May arise in young adults.
No gender predilection.
The commonest sites are the cerebellum, the region of the third ventricle, optic chiasma, thalamus and hypothalamus, and spinal cord. It may be multicentric
It’s the most common type of astrocytoma (90%).
Most frequent in young adults.
It represents about 80% of adult primary brain tumors.
It has a male predominance.
common sites are cerebral hemispheres especially frontal, temporal lobes, and spinal cord in adults and brain stem in children. Site
 Pilocytic astrocytomas (WHO Grade I) Diffuse astrocytomas (WHO Grade II)
Pilocytic astrocytomas (WHO Grade I) Diffuse astrocytomas (WHO Grade II)
Relatively benign tumor. They grow very slowly. It is rarely infiltrative. They have good prognosis and associated with long-term survival.
Median survival is 6-8 years but rarely has rapid progression and death.
Discrete and often cystic. The tumor is often microcystic or macrocystic, and may have mural nodule.
Diffuse astrocytomas are gray white in color with poorly demarcated infiltrative border that may expand and distort the brain tissue.
The tumor may have spongy or gelatinous appearance, microcysts, and calcification.

The tumor is of low to moderate cellularity, Bipolar neoplastic cells with elongated hair-like GFAP positive processes that are arranged in parallel bundles that resemble mats of hair. Nuclei are elongated.
Rosenthal fibers (tapered corkscrew shaped, brightly eosinophilic, hyaline masses), associated with eosinophilic protein droplets (resembling foamy macrophages) and microcystes are often present.

Diffuse astrocytoma is composed of well-differentiated fibrillary astrocytes in a background of a loosely structured, often microcystic tumor matrix.
The cellularity is moderately increased compared with that of normal brain, and nuclear atypia is a characteristic feature. Mitotic activity is generally absent.

A diffusely Infiltrating astrocytoma with focal or dispersed anaplasia and significant proliferative activity. Anaplastic astrocytomas can arise from lower-grade diffuse astrocytomas, but are more commonly diagnosed without indication of a less-malignant precursor lesion.
Aggressive tumor of adults. Mean age is 45 years. It has male predominance.
A high-grade glioma with predominantly astrocytic differentiation;
1. Featuring nuclear atypia. 2. Cellular pleomorphism (in most cases). 3. Mitotic activity 4. A typically diffuse growth 5. Pattern microvascular proliferation and/or necrosis. The most malignant astrocytoma.

The tumor arises in the cerebral hemispheres. Usually supratentorial but can arise anywhere in the CNS. Preferred sites are frontal and temporal lobes, brain stem, and spinal cord. It is uncommon in the cerebellum.
Ill-defined with blurred margins. It may have clearer distinction from surrounding brain structures than low grade diffuse astrocytomas.
Usually supratentorial; mainly affects cerebral hemispheres and basal ganglia.
Uncommon in the cerebellum, rare in the spinal cord. Glioblastoma of the brain stem is infrequent and often affects children.
Rapidly growing solitary, large, poorly delineated tumors that may have pseudo-capsule. Usually intraparenchymal, infrequently superficial.
It may have spongy or gelatinous appearance. Microcysts, and calcification may be present.
The tumor may cross the midline through corpus callosum, or anterior commissure to produce a "butterfly" lesion.
It is named "Multiforme" due to variegated gross appearance (The cut section is variegated; shows peripheral firm, grayish white areas, soft yellow necrotic central areas, recent and old hemorrhage, cysts formation due to liquefied necrotic tumor tissue).
Often there is peritumoral edema.

Similar to grade II tumors but the tumor shows: high cellularity, more atypia; nuclear anaplasia (pleomorphism and hyperchromatism), and mitotic activity. Vascular proliferation and necrosis are absent.
Glioblastoma has a wide range of histological appearance. It is a high grade tumor showing: high cellularity, cellular pleomorphism, nuclear atypia, mitotic activity, bizarre nuclei and multinucleated tumor giant cells.

Glioblastoma may show karyorrhexis, and necrosis. Pseudopalisading necrosis (tumor cells around serpiginous necrotic zones and/or vascular proliferation).
There is also microvascular proliferation (formerly called "endothelial proliferation") with thickened vascular walls due to endothelial cell hyperplasia and formation of multiple lumina resembling glomerulus.
Oligodendrogliomas are uncommon gliomas of oligodendroglial origin that may develop in isolation or may be mixed with other glial cells.
slowly growing tumors of children and young adult.

They make up about 5% of adult intracranial gliomas and up to 10% of childhood tumors of the CNS.
Their occurrence seems to peak at the age of 5 years and then again at the age of 35 years.
Oligodendrogliomas occur in the cerebral hemispheres, most commonly in the frontal lobes, the thalamus or within the ventricles. They rarely affect the spinal cord or the cerebellum.
Oligodendroglioma is a welldefined mass, composed of soft, gray-pink tissue that often acquires gelatinous consistency owing to the accumulation of myxoid matrix.
It has frequent cystic changes and contains small foci of dense calcification that are palpably gritty or even rock-hard
Ependymoma arises from the ependymal cells lining the ventricles of the CNS.
In pediatrics the tumor is usually located intracranially, while in adults it is spinal. The commonest location of intracranial ependymoma is the fourth ventricle
Ependymomas present as firm nodules of various sizes, in most cases, the diameter does not exceed 1-2 cm.
These tumors are solid or papillary, gray, fleshy mass extending from the floor of the ventricle.
Sheets of rounded or polygonal cells with small rounded nuclei containing finely granular chromatin surrounded by perinuclear pale halo of cytoplasm. (a honeycomb or friedegg appearance)
No mitotic activity. Stroma is scanty with numerous thin walled blood vessels.
Ependymomas are composed of cells with regular, round to oval nuclei.
There is a variably dense fibrillary background.

Tumor cells may form gland-like round or elongated structures that resemble the embryologic ependymal canal, with long, delicate processes extending into the lumen.
The cytoplasmic processes of ependymal cells may condense either around blood vessels to form pseudo-rosettes with an intervening zone consisting of thin ependymal processes directed toward the wall of the vessel, or around central lumen to form true rosettes.
Oligodendroglioma is a rare slowly growing tumor. It is a WHO Grade II tumor. has a better prognosis than astrocytoma.
Note: Diffuse astrocytomas can arise anywhere in the brain but it’s uncommon in the cerebellum.


The tumor originating in the part of the brain that is towards the back and the bottom, on the floor of the skull, in the cerebellum, or posterior fossa.
The most common location is the cerebellum in the region of roof of fourth ventricle, in the midline of cerebellum, in the vermis, between the brainstem and the cerebellum and in the cerebellar hemispheres.
Medulloblastomas are rapidly growing tumors that invades locally, and spread through the CSF to the meninges,
ventricles and subarachnoid space.
medulloblastomas correspond histologically to WHO grade IV.
The tumor frequently metastasizes to different locations along the surface of the brain and spinal cord.
Metastasis all the way down to the cauda equina at the base of the spinal cord is termed "drop metastasis".
Medulloblastomas has a tendency for widespread metastases to extraneural sites such as to lungs, liver, vertebrae and pelvis.
The tumor is usually a circumscribed cystic mass with a mural nodule.
The cyst contains hemorrhagic fluid.

The tumor typically protrudes into the fourth ventricle as a soft, grey white mass obstructing the pathway of the CSF.
The tumor may invade the surface of the cerebellum. The cut surface is fleshy grayish pink mass that shows hemorrhage and necrosis.
The tumor disseminates through the CSF.
Medulloblastoma is a cellular tumor composed of small, poorly differentiated cells with scanty cytoplasm and ill-defined cytoplasmic processes.
The nuclei are hyperchromatic, round or oval. The cells have a tendency to be arranged around blood vessels and occasionally forms pseudorosettes; Homer-Wright rosettes, consisting of tumor cells surrounding a fibrillar area. Both perivascular pseudorosette and Homer Wright rosettes formation are highly characteristic of medulloblastomas and is seen in up to half of the cases. Also, the classic rosette with tumor cells around a central lumen can be seen. Another characteristic of the tumor is differentiation into glial or neuronal elements.
Sites:

Their most common sites of meningiomas are in the front half of the head and include: lateral cerebral convexities, midline along the falx cerebri adjacent to the major venous sinuses parasagittally, and olfactory groove. Less frequent sites are: within the cerebral ventricles, foramen magnum, cerebello-pontine angle and the spinal cord.

Gross Picture:

Meningioma is firm, solid, well circumscribed, variable sized (1-10 cm in diameter), round or oval, capsulated tumor. The tumor is generally firmly attached to the dura and indents the surface of the brain but rarely ever invades it (compresses the underlying brain tissue but easily separated from it). Extension into the overlying bone may occur.

The tumor consists of solid masses of polygonal cells with indistinct cytoplasmic borders (syncytial appearance).

The cells have round to oval, central nuclei with inconspicuous nucleoli, and abundant, finely granular lightly eosinophilic cytoplasm.
Some amount of collagenous stroma is present that divides the tumor into irregular lobules.
The whorls and psammoma bodies are often sparse. Its syncytial appearance, whorls, psammoma bodies, and its usual dural attachment distinguish this type of meningioma from other neoplasms.
The margin of a meningioma with CNS parenchyma is more discrete than that of a glioma.
This subtype is uncommon in pure form, this meningioma variant consists of spindle cells forming parallel, storiform and interlacing bundles in a collagenrich matrix.
Whorl formation and psammoma bodies are infrequent.

Nuclear features characteristic of meningothelial meningiomas are often found focally as well.
These common tumors feature the coexistence of meningothelial and fibrous patterns as well as transitions between these patterns.
Vaguely lobular and fascicular arrangements often appear side by side in association with conspicuous tight whorls and psammoma bodies.
These are often found in the spinal region. They are crowded with psammoma bodies. This benign variant is recognized as meningioma by finding syncytial cells between the conspicuous, concentrically laminated psammoma bodies.

This tumor has features typical of a benign meningioma but in addition contains many small or large vascular channels, that may predominate over its meningothelial elements. vascular channels may be small- or medium-sized, thin walled or thick. The majority are small with markedly hyalinized walls. Moderate to marked degenerative nuclear atypia is common, but nearly most of such tumors are histologically and clinically benign. Angiomatous meningiomas have relative high male to female ratio, more frequent peritumoral edema, and rich blood vessels.
(WHO grade II)

The WHO/Mayo Clinic criteria are applied whether present as focal findings or in more diffuse form. In this scheme, atypical meningiomas are defined as: 1)Meningiomas containing four (4) or more mitotic figures per 10 high power microscopic fields or 2)Meningiomas exhibiting at least three (3) of the following features:

Hypercellularity.
Patternless, sheet-like growth.
Macronucleoli.

Small cell components with high nuclear-cytoplasmic ratio.
Zones of necrosis.

(WHO grade III) are defined as: Meningiomas containing 20 or more mitoses per 10 high-power microscopic fields or Meningiomas exhibiting a loss of differentiated features resulting in carcinoma, melanoma, or sarcoma like appearances. We should note that WHO grade II status is accorded clear cell and chordoid meningiomas, while papillary and rhabdoid variants are designated as WHO grade III tumors.

